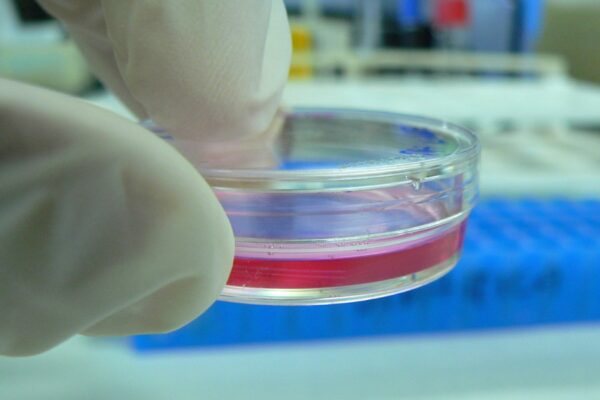
Cultivos in vitro para microbiología

La posibilidad de aislar y mantener un microorganismo en cultivos no es un hecho trivial ni automático, sino que depende de manera directa de las características biológicas propias del agente infeccioso, de sus exigencias metabólicas y ambientales, y de las condiciones en las que se obtiene y procesa la muestra clínica. Cada microorganismo posee requerimientos específicos de nutrientes, temperatura, atmósfera y tiempo de incubación, por lo que un método de cultivo inadecuado puede conducir a resultados falsamente negativos, aun cuando el patógeno esté presente en el paciente.
Algunas bacterias patógenas ilustran con claridad esta dependencia entre biología y técnicas de cultivo. Legionella, un agente etiológico relevante de infecciones respiratorias, no pudo ser cultivada durante años debido a que los medios convencionales carecían de componentes esenciales para su metabolismo. Solo cuando se reconoció su necesidad de hierro y de L-cisteína fue posible diseñar medios suplementados que permitieran su recuperación y crecimiento. De manera similar, Campylobacter, un patógeno intestinal de gran importancia clínica, pasó desapercibido en muestras fecales hasta que se estableció que requería medios altamente selectivos, incubación a una temperatura elevada cercana a la fisiológica de las aves, y una atmósfera con concentraciones reducidas de oxígeno. Sin estas condiciones específicas, el microorganismo no se multiplica o queda superado por otras bacterias más resistentes.
El sitio de infección también influye de forma determinante en el éxito del cultivo. En el síndrome de choque tóxico estafilocócico, Staphylococcus aureus produce una toxina que se libera al torrente sanguíneo desde un foco localizado en cualquier tejido del organismo. En este contexto, los hemocultivos suelen resultar negativos porque la bacteria no circula de manera constante en la sangre. En cambio, el cultivo del sitio donde el microorganismo se encuentra colonizando o infectando permite su detección directa. Este ejemplo pone de manifiesto que la elección del tipo de muestra es tan importante como el medio de cultivo utilizado.
En muchas infecciones, como las gastrointestinales, faríngeas o uretrales, el agente causal se encuentra mezclado con una abundante microbiota normal propia de ese nicho anatómico. Esta coexistencia dificulta la identificación del patógeno, ya que los microorganismos comensales suelen crecer con mayor rapidez. Para resolver este problema, se han desarrollado medios selectivos y diferenciales que inhiben el crecimiento de la flora habitual y favorecen la detección de bacterias clínicamente relevantes. Sin estos medios especializados, el patógeno puede quedar enmascarado y pasar inadvertido.
La respuesta inmunitaria del huésped constituye otro factor limitante. Tanto la inmunidad innata como la adaptativa pueden reducir la carga microbiana hasta niveles muy bajos, lo que obliga a emplear técnicas de cultivo altamente sensibles. En ciertas infecciones, la cantidad de microorganismos presentes es extremadamente reducida. En la sepsis, por ejemplo, la concentración bacteriana en sangre suele ser inferior a un microorganismo por mililitro. Por esta razón, la recuperación de bacterias y levaduras requiere la inoculación de grandes volúmenes de sangre en caldos de enriquecimiento que permitan la multiplicación progresiva del patógeno hasta niveles detectables.
La calidad de los medios de cultivo es un aspecto crítico que no puede descuidarse. Es imprescindible garantizar que dichos medios conserven su capacidad de sostener el crecimiento microbiano conforme a su diseño original. En la actualidad, la mayoría de los laboratorios no elaboran sus propios medios, sino que los adquieren de fabricantes comerciales especializados. Esta práctica ofrece ventajas en términos de estandarización y control de calidad, pero implica que los medios no siempre son de producción reciente. Aunque esto rara vez representa un problema, puede afectar la recuperación de microorganismos particularmente exigentes, como Bordetella pertussis. Por ello, los laboratorios que realizan estudios microbiológicos avanzados suelen mantener la capacidad de preparar cantidades limitadas de medios especiales a partir de formulaciones deshidratadas, una tarea que puede llevarse a cabo con relativa facilidad y que resulta esencial para el diagnóstico de infecciones causadas por patógenos fastidiosos.
Tipos de medios de cultivo
Los medios de cultivo constituyen herramientas fundamentales en microbiología clínica, ya que permiten reproducir en el laboratorio las condiciones necesarias para que los microorganismos se multipliquen y puedan ser detectados, aislados e identificados. Debido a la enorme diversidad metabólica y fisiológica de los agentes infecciosos, no existe un medio único capaz de satisfacer las necesidades de todos ellos. Por esta razón, los medios de cultivo se clasifican en diferentes tipos, según su composición y el propósito diagnóstico para el cual han sido diseñados.
Los medios enriquecidos no selectivos tienen como objetivo favorecer el crecimiento de una amplia variedad de microorganismos, incluidos aquellos con requerimientos nutricionales moderados, sin ejercer presión inhibitoria sobre la mayoría de las bacterias. Estos medios parten de una base nutritiva general a la que se añaden componentes complejos que aportan factores de crecimiento esenciales, como proteínas, lípidos, vitaminas y cofactores. El agar sangre es un ejemplo representativo, ya que la adición de sangre proporciona nutrientes adicionales y permite, además, observar patrones de hemólisis útiles para la caracterización bacteriana. El agar chocolate, derivado del calentamiento de la sangre, libera factores intracelulares indispensables para bacterias más exigentes desde el punto de vista metabólico. En el caso del agar Sabouraud con dextrosa, su formulación favorece el desarrollo de hongos al proporcionar un alto contenido de carbohidratos y un pH que limita el crecimiento bacteriano, sin llegar a ser estrictamente selectivo.
Los medios selectivos están diseñados para facilitar la recuperación de un microorganismo específico cuando este se encuentra mezclado con una flora microbiana abundante, como ocurre con frecuencia en muestras fecales, respiratorias o cutáneas. Para lograrlo, estos medios incorporan sustancias inhibitorias que restringen el crecimiento de grupos microbianos no deseados, permitiendo que el patógeno de interés se multiplique con mayor facilidad. La selección puede basarse en diferencias de resistencia a sales, colorantes, antibióticos u otros agentes químicos, aprovechando características fisiológicas particulares del microorganismo buscado.
Muchos medios selectivos incorporan, además, elementos que los convierten en diferenciales. Estos medios no solo favorecen o inhiben el crecimiento de ciertos organismos, sino que también permiten distinguirlos visualmente mediante reacciones bioquímicas simples. La inclusión de un carbohidrato específico y un indicador de pH es una estrategia común, ya que la fermentación del sustrato produce cambios de color que facilitan la identificación preliminar. El agar MacConkey ejemplifica este enfoque al permitir el crecimiento de bacterias gramnegativas y diferenciar aquellas capaces de fermentar lactosa de las que no lo hacen. De manera similar, el agar manitol salado explota la tolerancia de los estafilococos a altas concentraciones de sal como mecanismo selectivo, mientras que la fermentación del manitol actúa como rasgo diferencial. El agar xilosa lisina desoxicolato combina agentes inhibitorios con sustratos metabólicos que generan reacciones características útiles para la detección inicial de Salmonella y Shigella en cultivos entéricos.
Existen también medios selectivos enriquecidos, como el agar inhibitorio para mohos, que incorporan nutrientes adicionales para favorecer el crecimiento de hongos patógenos y, al mismo tiempo, contienen antibióticos que suprimen la proliferación bacteriana contaminante. Este tipo de formulaciones resulta esencial cuando el organismo de interés crece lentamente y podría ser fácilmente sobrepasado por otros microorganismos más competitivos.
Los medios especializados abarcan una amplia gama de formulaciones desarrolladas para la detección de microorganismos con requerimientos muy particulares o que suelen encontrarse en entornos microbiológicos complejos. Estos medios pueden incluir nutrientes específicos, atmósferas controladas, indicadores metabólicos o sistemas de enriquecimiento diseñados para maximizar la recuperación del patógeno. Su uso refleja el conocimiento detallado de la fisiología microbiana y responde a la necesidad de adaptar el diagnóstico microbiológico a la diversidad y complejidad de los agentes infecciosos.
Cultivos celulares
El estudio y la identificación de ciertos agentes infecciosos requieren sistemas de cultivo que vayan más allá de los medios artificiales tradicionales, ya que algunos microorganismos poseen una dependencia absoluta de la célula viva para su multiplicación. En este grupo se incluyen todas las especies virales y determinadas bacterias, cuyo metabolismo está tan estrechamente ligado al de la célula huésped que no pueden reproducirse de manera autónoma en medios inertes. Para estos microorganismos, el cultivo celular constituye una herramienta esencial que permite reproducir, en condiciones controladas, el entorno biológico necesario para su replicación.
El desarrollo de los cultivos celulares como método microbiológico se consolidó a mediados del siglo veinte, cuando se demostró que las células de mamífero podían mantenerse vivas y funcionales fuera del organismo y utilizarse como sustrato para la multiplicación viral. A partir de este avance, la técnica se perfeccionó y amplió, permitiendo el aislamiento y estudio de una gran variedad de microorganismos estrictamente intracelulares. El principio fundamental de estos sistemas es ofrecer células metabólicamente activas capaces de proporcionar energía, macromoléculas y maquinaria biosintética que el microorganismo no puede generar por sí mismo.
Las células utilizadas en cultivo pueden organizarse de distintas maneras según su origen y características biológicas. Algunas se adhieren a superficies sólidas y proliferan formando una capa continua de células, lo que facilita la observación directa de los cambios inducidos por la infección. Otras crecen en suspensión dentro de medios líquidos, lo que resulta útil para ciertos tipos de estudios y para la producción a gran escala de virus. La elección del sistema depende tanto del microorganismo que se desea aislar como de los objetivos diagnósticos o experimentales.
Desde el punto de vista de su mantenimiento, los cultivos celulares se dividen en líneas establecidas y cultivos primarios. Las líneas establecidas derivan de tejidos que han adquirido la capacidad de dividirse de manera indefinida bajo condiciones apropiadas. Estas células presentan gran estabilidad y reproducibilidad, por lo que se encuentran disponibles de forma comercial y son ampliamente utilizadas en laboratorios clínicos y de investigación. En contraste, los cultivos primarios se obtienen directamente de tejidos recientes y conservan muchas de las características originales del órgano del que proceden. Sin embargo, su vida útil es limitada, ya que solo pueden dividirse durante un número reducido de ciclos antes de perder viabilidad, lo que obliga a prepararlos poco antes de su uso.
La interacción entre el microorganismo y la célula cultivada es altamente específica y depende, en gran medida, de la presencia de receptores adecuados en la superficie celular. Esta especificidad explica por qué ciertos virus o bacterias solo pueden infectar determinadas líneas celulares y no otras. La capacidad de un agente infeccioso para unirse, penetrar y replicarse en una célula concreta constituye, por tanto, un criterio valioso para su identificación. Además, la infección puede manifestarse de distintas formas: algunos microorganismos provocan alteraciones estructurales evidentes, como la destrucción de la célula o cambios morfológicos característicos, mientras que otros establecen un crecimiento coordinado dentro de la célula sin producir daño inmediato.
La observación de estos efectos, junto con el patrón de susceptibilidad de las distintas líneas celulares, permite inferir la identidad del agente infeccioso con un alto grado de precisión. De este modo, los cultivos celulares no solo representan un medio para la multiplicación de microorganismos estrictamente intracelulares, sino también una herramienta diagnóstica y experimental que aprovecha la relación íntima entre el patógeno y su célula huésped.

Fuente y lecturas recomendadas:
- Madigan, M. T., Martinko, J. M., Bender, K. S., Buckley, D. H., & Stahl, D. A. (2018). Brock biology of microorganisms (15th ed.). Pearson.
- Murray, P. R., Rosenthal, K. S., & Pfaller, M. A. (2025). Medical microbiology (10th ed.). Elsevier.
- Postgate, J. (2000). Microbes and man (4th ed.). Cambridge University Press.
- Riedel, S., Hobden, J. A., Miller, S., Morse, S. A., Mietzner, T. A., Detrick, B., Mitchell, T. G., Sakanari, J. A., Hotez, P., & Mejía, R. (2020). Microbiología médica (28ª ed.). McGraw-Hill Interamericana Editores.